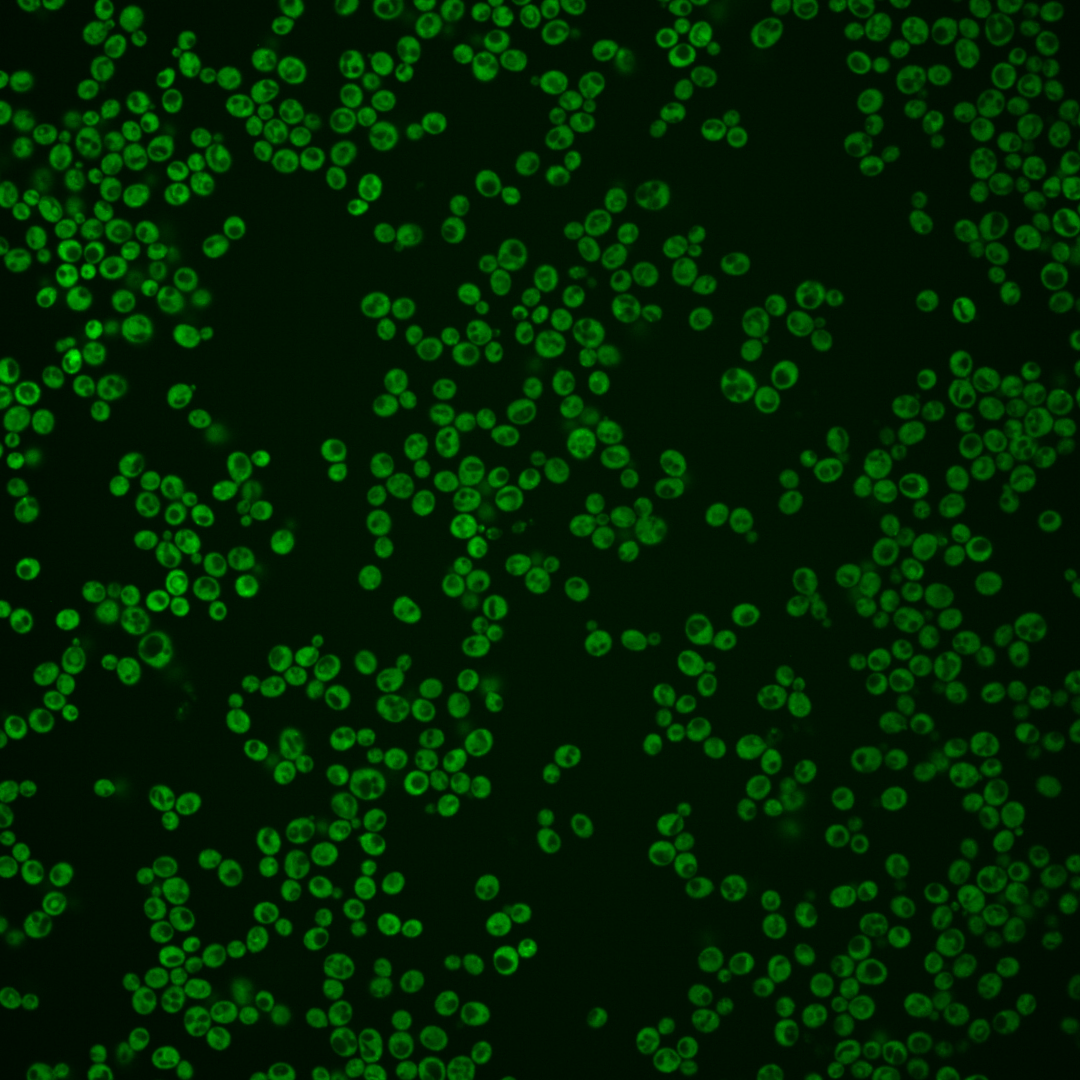
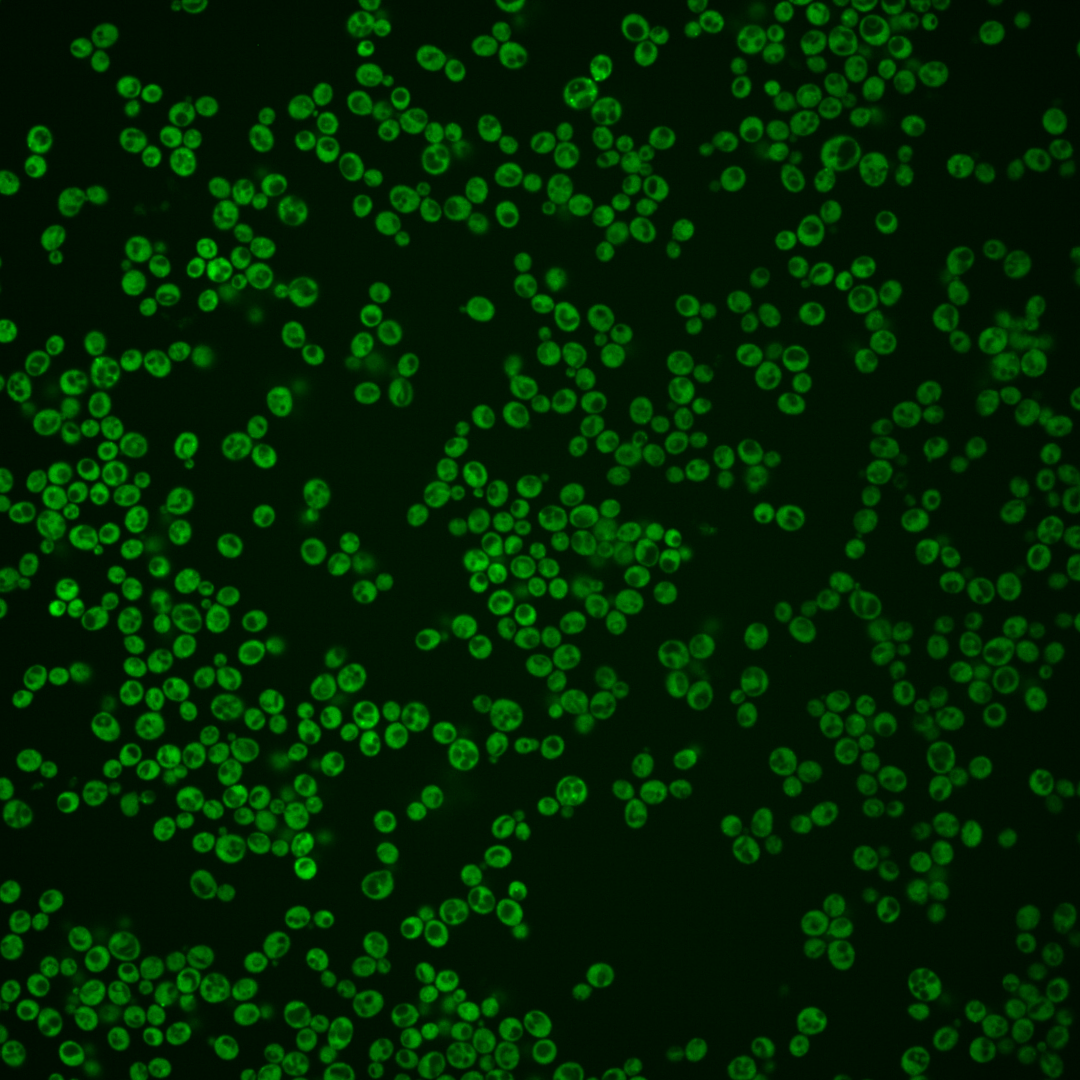

| Standard name | |
|---|---|
| Human Ortholog | |
| Description | Lsm (Like Sm) protein; part of heteroheptameric complexes (Lsm2p-7p and either Lsm1p or 8p): cytoplasmic Lsm1p complex involved in mRNA decay; nuclear Lsm8p complex part of U6 snRNP and possibly involved in processing tRNA, snoRNA, and rRNA; protein abundance increases and forms cytoplasmic foci in response to DNA replication stress |
Micrographs




















































































Sub-cellular Localization
Yeast GFP Assignment
Protein Abundance
Localization Change
External localization resources
| ensLOC | DeepLoc | |||||||||||||||||||||||
|---|---|---|---|---|---|---|---|---|---|---|---|---|---|---|---|---|---|---|---|---|---|---|---|---|
| Localization | WT1 | WT2 | WT3 | RAP60 | RAP140 | RAP220 | RAP300 | RAP380 | RAP460 | RAP540 | RAP620 | RAP700 | HU80 | HU120 | HU160 | rpd3Δ_1 | rpd3Δ_2 | rpd3Δ_3 | WT1 | WT2 | WT3 | AF100 | AF140 | AF180 |
| Cortical Patches | 1 | 0 | 3 | 4 | 0 | 5 | – | 6 | 7 | 17 | 9 | 8 | 88 | 84 | 123 | 0 | 0 | 0 | 0 | 0 | 0 | 0 | 1 | 3 |
| Bud | 1 | 1 | 15 | 6 | 4 | 3 | – | 4 | 9 | 5 | 2 | 9 | 34 | 42 | 35 | 0 | 0 | 0 | 0 | 0 | 1 | 1 | 0 | 3 |
| Bud Neck | 0 | 0 | 0 | 0 | 0 | 0 | – | 0 | 0 | 0 | 0 | 0 | 0 | 0 | 0 | 0 | 0 | 0 | 0 | 0 | 1 | 0 | 0 | 0 |
| Bud Site | 0 | 0 | 0 | 0 | 0 | 0 | – | 0 | 0 | 0 | 0 | 0 | 0 | 0 | 0 | 0 | 0 | 0 | – | – | – | – | – | – |
| Cell Periphery | 10 | 26 | 17 | 28 | 12 | 7 | – | 14 | 36 | 38 | 37 | 42 | 14 | 15 | 30 | 10 | 15 | 20 | 0 | 0 | 1 | 1 | 1 | 1 |
| Cytoplasm | 498 | 534 | 670 | 354 | 299 | 468 | – | 308 | 471 | 438 | 364 | 377 | 322 | 277 | 289 | 139 | 168 | 176 | 494 | 523 | 644 | 310 | 260 | 348 |
| Endoplasmic Reticulum | 11 | 9 | 5 | 21 | 13 | 55 | – | 47 | 52 | 97 | 72 | 101 | 30 | 25 | 24 | 5 | 1 | 6 | 7 | 9 | 24 | 13 | 19 | 28 |
| Endosome | 1 | 0 | 0 | 0 | 0 | 1 | – | 1 | 0 | 0 | 0 | 1 | 45 | 62 | 57 | 0 | 0 | 1 | 4 | 1 | 4 | 1 | 2 | 7 |
| Golgi | 1 | 0 | 0 | 0 | 0 | 0 | – | 1 | 0 | 1 | 1 | 1 | 92 | 64 | 124 | 0 | 0 | 1 | 1 | 2 | 1 | 0 | 0 | 5 |
| Mitochondria | 4 | 1 | 7 | 25 | 25 | 57 | – | 70 | 140 | 139 | 121 | 179 | 0 | 2 | 0 | 1 | 6 | 1 | 2 | 1 | 5 | 0 | 0 | 2 |
| Nucleus | 3 | 0 | 3 | 2 | 1 | 3 | – | 2 | 1 | 8 | 5 | 4 | 0 | 1 | 0 | 2 | 0 | 1 | 2 | 0 | 2 | 0 | 0 | 1 |
| Nuclear Periphery | 0 | 0 | 0 | 0 | 0 | 1 | – | 1 | 2 | 16 | 1 | 1 | 0 | 0 | 0 | 1 | 0 | 0 | 0 | 1 | 2 | 1 | 0 | 1 |
| Nucleolus | 0 | 0 | 0 | 0 | 0 | 0 | – | 5 | 0 | 3 | 1 | 1 | 5 | 3 | 5 | 0 | 0 | 0 | 0 | 0 | 0 | 0 | 0 | 0 |
| Peroxisomes | 0 | 0 | 0 | 0 | 0 | 0 | – | 0 | 0 | 0 | 0 | 0 | 1 | 5 | 5 | 0 | 0 | 0 | 0 | 0 | 0 | 0 | 0 | 0 |
| SpindlePole | 0 | 0 | 0 | 0 | 0 | 0 | – | 0 | 0 | 0 | 0 | 0 | 18 | 23 | 40 | 0 | 0 | 0 | 0 | 0 | 0 | 0 | 1 | 2 |
| Vac/Vac Membrane | 5 | 8 | 0 | 3 | 8 | 16 | – | 78 | 50 | 77 | 32 | 33 | 3 | 6 | 13 | 3 | 11 | 5 | 5 | 9 | 10 | 6 | 4 | 4 |
| Unique Cell Count | 516 | 551 | 681 | 403 | 342 | 577 | 492 | 692 | 756 | 562 | 672 | 526 | 491 | 582 | 149 | 184 | 188 | 526 | 557 | 708 | 340 | 296 | 419 | |
| Labelled Cell Count | 535 | 579 | 720 | 443 | 362 | 616 | 537 | 768 | 839 | 645 | 757 | 652 | 609 | 745 | 161 | 201 | 211 | 526 | 557 | 708 | 340 | 296 | 419 | |
Yeast GFP Assignment
Protein Abundance
| Screen | WT1 | WT2 | WT3 | RAP60 | RAP140 | RAP220 | RAP300 | RAP380 | RAP460 | RAP540 | RAP620 | RAP700 | HU80 | HU120 | HU160 | rpd3Δ_1 | rpd3Δ_2 | rpd3Δ_3 | AF100 | AF140 | AF180 |
|---|---|---|---|---|---|---|---|---|---|---|---|---|---|---|---|---|---|---|---|---|---|
| Mean Cell GFP Intensity (1e-4) | 14.6 | 18.2 | 9.8 | 12.7 | 7.9 | 11.7 | – | 11.3 | 11.0 | 11.2 | 11.4 | 11.3 | 18.3 | 18.2 | 18.4 | 20.5 | 21.2 | 21.0 | 17.0 | 17.5 | 18.1 |
| Std Deviation (1e-4) | 2.5 | 2.7 | 1.7 | 2.0 | 1.9 | 2.2 | – | 2.5 | 2.4 | 2.4 | 2.6 | 2.5 | 2.7 | 3.1 | 3.1 | 6.7 | 6.6 | 5.4 | 2.8 | 3.3 | 3.6 |
| Intensity Change (Log2) | – | – | – | 0.37 | -0.31 | 0.26 | – | 0.2 | 0.17 | 0.19 | 0.22 | 0.2 | 0.9 | 0.89 | 0.91 | 1.06 | 1.11 | 1.09 | 0.79 | 0.83 | 0.88 |
Localization Change
| Localization | RAP60 | RAP140 | RAP220 | RAP300 | RAP380 | RAP460 | RAP540 | RAP620 | RAP700 | HU80 | HU120 | HU160 | rpd3Δ_1 | rpd3Δ_2 | rpd3Δ_3 |
|---|---|---|---|---|---|---|---|---|---|---|---|---|---|---|---|
| Cortical Patches | 0 | 0 | 0 | – | 0 | 0 | 2.9 | 2.1 | 1.5 | 10.6 | 10.7 | 12.2 | 0 | 0 | 0 |
| Bud | -0.8 | -1.2 | -2.5 | – | -1.9 | -1.3 | -2.5 | -2.8 | -1.2 | 3.7 | 5.0 | 3.5 | 0 | 0 | 0 |
| Bud Neck | 0 | 0 | 0 | – | 0 | 0 | 0 | 0 | 0 | 0 | 0 | 0 | 0 | 0 | 0 |
| Bud Site | 0 | 0 | 0 | – | 0 | 0 | 0 | 0 | 0 | 0 | 0 | 0 | 0 | 0 | 0 |
| Cell Periphery | 3.6 | 0.9 | -1.7 | – | 0.4 | 2.6 | 2.5 | 3.5 | 3.4 | 0.2 | 0.6 | 2.5 | 0 | 3.6 | 4.9 |
| Cytoplasm | -7.3 | -7.4 | -10.4 | – | -16.2 | -15.0 | -18.2 | -15.8 | -18.6 | -16.7 | -18.0 | -20.2 | -3.6 | -4.9 | -3.6 |
| Endoplasmic Reticulum | 4.7 | 3.5 | 7.3 | – | 7.2 | 6.3 | 8.9 | 8.8 | 9.8 | 5.1 | 4.7 | 4.0 | 0 | 0 | 0 |
| Endosome | 0 | 0 | 0 | – | 0 | 0 | 0 | 0 | 0 | 7.8 | 9.5 | 8.4 | 0 | 0 | 0 |
| Golgi | 0 | 0 | 0 | – | 0 | 0 | 0 | 0 | 0 | 11.4 | 9.7 | 12.7 | 0 | 0 | 0 |
| Mitochondria | 4.9 | 5.4 | 7.1 | – | 9.0 | 11.5 | 10.9 | 11.8 | 13.7 | 0 | 0 | 0 | 0 | 0 | 0 |
| Nucleus | 0 | 0 | 0 | – | 0 | 0 | 1.3 | 0 | 0 | 0 | 0 | 0 | 0 | 0 | 0 |
| Nuclear Periphery | 0 | 0 | 0 | – | 0 | 0 | 3.8 | 0 | 0 | 0 | 0 | 0 | 0 | 0 | 0 |
| Nucleolus | 0 | 0 | 0 | – | 0 | 0 | 0 | 0 | 0 | 0 | 0 | 0 | 0 | 0 | 0 |
| Peroxisomes | 0 | 0 | 0 | – | 0 | 0 | 0 | 0 | 0 | 0 | 0 | 0 | 0 | 0 | 0 |
| SpindlePole | 0 | 0 | 0 | – | 0 | 0 | 0 | 0 | 0 | 4.9 | 5.7 | 7.0 | 0 | 0 | 0 |
| Vacuole | 0 | 0 | 4.4 | – | 10.8 | 7.1 | 8.6 | 6.3 | 5.9 | 0 | 0 | 3.9 | 0 | 0 | 0 |
External localization resources
Images






























Protein Concentration and Protein Localization Data
| R1 | R2 | R3 | ||||||||||||||||
|---|---|---|---|---|---|---|---|---|---|---|---|---|---|---|---|---|---|---|
| G1 Pre-START | G1 Post-START | S/G2 | Metaphase | Anaphase | Telophase | G1 Pre-START | G1 Post-START | S/G2 | Metaphase | Anaphase | Telophase | G1 Pre-START | G1 Post-START | S/G2 | Metaphase | Anaphase | Telophase | |
| Concentration | 15.854 | 18.6895 | 17.9195 | 17.0192 | 17.4881 | 16.9128 | 10.5521 | 13.7667 | 12.57 | 12.2305 | 10.5907 | 12.2298 | 15.1246 | 17.1531 | 16.5451 | 15.4794 | 15.3272 | 16.0252 |
| Actin | 0.002 | 0.0008 | 0.0003 | 0.0002 | 0.0006 | 0.0004 | 0.0118 | 0.0015 | 0.0078 | 0.0006 | 0.0116 | 0.0034 | 0.0003 | 0.0004 | 0.0004 | 0.0002 | 0.0001 | 0.0001 |
| Bud | 0.0002 | 0.0002 | 0.0001 | 0.0001 | 0.0001 | 0.0001 | 0.0006 | 0.0005 | 0.0007 | 0.0021 | 0.0054 | 0.0008 | 0.0004 | 0.0001 | 0.0001 | 0.0001 | 0.0001 | 0 |
| Bud Neck | 0.0003 | 0.0003 | 0.0003 | 0.0005 | 0.0006 | 0.0011 | 0.0008 | 0.0002 | 0.0017 | 0.0006 | 0.0007 | 0.0009 | 0.0008 | 0.0003 | 0.0002 | 0.0004 | 0.0004 | 0.0007 |
| Bud Periphery | 0.0001 | 0.0002 | 0 | 0 | 0 | 0.0001 | 0.0005 | 0.0001 | 0.0006 | 0.0006 | 0.0047 | 0.0004 | 0.0007 | 0 | 0 | 0 | 0 | 0 |
| Bud Site | 0.0001 | 0.0004 | 0.0001 | 0.0001 | 0.0001 | 0.0001 | 0.0013 | 0.003 | 0.0019 | 0.0007 | 0.0056 | 0.0001 | 0.0002 | 0.0002 | 0.0001 | 0 | 0 | 0 |
| Cell Periphery | 0.0001 | 0.0002 | 0.0001 | 0 | 0.0001 | 0.0001 | 0.0002 | 0.0001 | 0.0001 | 0.0001 | 0.0005 | 0 | 0.0003 | 0.0001 | 0 | 0 | 0 | 0 |
| Cytoplasm | 0.9297 | 0.9741 | 0.9726 | 0.9384 | 0.9564 | 0.9367 | 0.8217 | 0.9615 | 0.9315 | 0.8868 | 0.9015 | 0.9422 | 0.9274 | 0.9749 | 0.979 | 0.9461 | 0.964 | 0.9625 |
| Cytoplasmic Foci | 0.0041 | 0.003 | 0.0028 | 0.0057 | 0.0035 | 0.0047 | 0.0315 | 0.008 | 0.0144 | 0.0066 | 0.0046 | 0.0127 | 0.0061 | 0.0031 | 0.0031 | 0.0045 | 0.0051 | 0.0039 |
| Eisosomes | 0 | 0 | 0 | 0 | 0 | 0 | 0.0001 | 0 | 0 | 0 | 0 | 0 | 0 | 0 | 0 | 0 | 0 | 0 |
| Endoplasmic Reticulum | 0.0345 | 0.0097 | 0.0121 | 0.0287 | 0.0164 | 0.0319 | 0.0282 | 0.0111 | 0.0079 | 0.0755 | 0.0066 | 0.0148 | 0.0282 | 0.0118 | 0.0105 | 0.0243 | 0.0112 | 0.0194 |
| Endosome | 0.0089 | 0.0045 | 0.0045 | 0.0141 | 0.0104 | 0.0123 | 0.0493 | 0.006 | 0.0155 | 0.0118 | 0.0143 | 0.0127 | 0.0106 | 0.0035 | 0.0032 | 0.017 | 0.0099 | 0.0066 |
| Golgi | 0.0009 | 0.0012 | 0.0004 | 0.0007 | 0.0006 | 0.0011 | 0.0102 | 0.0015 | 0.0038 | 0.0007 | 0.001 | 0.0027 | 0.0005 | 0.0008 | 0.0003 | 0.0006 | 0.0003 | 0.0004 |
| Lipid Particles | 0.0001 | 0.0001 | 0 | 0 | 0.0001 | 0 | 0.0063 | 0.0002 | 0.0005 | 0.0001 | 0.0002 | 0.0001 | 0.0008 | 0.0001 | 0 | 0 | 0 | 0 |
| Mitochondria | 0.0006 | 0.0005 | 0.0002 | 0.0006 | 0.0003 | 0.0011 | 0.0071 | 0.0016 | 0.0023 | 0.0008 | 0.0008 | 0.0016 | 0.0006 | 0.0003 | 0.0002 | 0.0004 | 0.0003 | 0.0009 |
| None | 0.0014 | 0.0004 | 0.0004 | 0.0003 | 0.0004 | 0.0005 | 0.0044 | 0.0011 | 0.0021 | 0.002 | 0.003 | 0.0016 | 0.0062 | 0.0005 | 0.0004 | 0.0006 | 0.0007 | 0.0007 |
| Nuclear Periphery | 0.0077 | 0.0013 | 0.0024 | 0.0023 | 0.0035 | 0.0035 | 0.0062 | 0.0008 | 0.0027 | 0.0046 | 0.0214 | 0.001 | 0.0057 | 0.0016 | 0.0008 | 0.0015 | 0.0024 | 0.0014 |
| Nucleolus | 0 | 0 | 0 | 0 | 0 | 0 | 0.0002 | 0 | 0.0001 | 0 | 0.0002 | 0 | 0.0001 | 0 | 0 | 0 | 0 | 0 |
| Nucleus | 0.0038 | 0.0015 | 0.0017 | 0.0022 | 0.0025 | 0.0033 | 0.0042 | 0.0011 | 0.002 | 0.0028 | 0.0115 | 0.0016 | 0.0041 | 0.0013 | 0.0009 | 0.0015 | 0.0034 | 0.0018 |
| Peroxisomes | 0.0001 | 0 | 0 | 0.0001 | 0 | 0 | 0.0029 | 0.0004 | 0.0009 | 0.0001 | 0.0001 | 0.0016 | 0.0001 | 0 | 0 | 0 | 0 | 0 |
| Punctate Nuclear | 0.0002 | 0.0001 | 0.0001 | 0.0001 | 0.0001 | 0.0001 | 0.0038 | 0.0005 | 0.0006 | 0.0005 | 0.0017 | 0.0003 | 0.0007 | 0.0001 | 0.0001 | 0.0001 | 0.0002 | 0.0001 |
| Vacuole | 0.0044 | 0.0011 | 0.0015 | 0.0045 | 0.0034 | 0.0022 | 0.007 | 0.0007 | 0.0021 | 0.0025 | 0.0034 | 0.0012 | 0.0053 | 0.0009 | 0.0005 | 0.002 | 0.0014 | 0.001 |
| Vacuole Periphery | 0.0008 | 0.0002 | 0.0003 | 0.0013 | 0.0008 | 0.0007 | 0.0019 | 0.0002 | 0.0007 | 0.0006 | 0.0012 | 0.0005 | 0.001 | 0.0002 | 0.0001 | 0.0007 | 0.0004 | 0.0003 |
Sequencing Data
| R1 | R2 | |||||||||
|---|---|---|---|---|---|---|---|---|---|---|
| G1 Post-START | S/G2 | Metaphase | Anaphase | Telophase | G1 Post-START | S/G2 | Metaphase | Anaphase | Telophase | |
| Gene Expression | 49.1459 | 59.5227 | 48.3749 | 67.3693 | 57.5534 | 19.0137 | 47.2869 | 57.061 | 68.153 | 63.3825 |
| Translational Efficiency | 3.1628 | 2.3436 | 2.4887 | 2.3943 | 2.5327 | 8.7422 | 2.9782 | 2.4685 | 2.2959 | 2.683 |
Hit Data
| Dataset | Hit |
|---|---|
| Protein Concentration | ✘ |
| Protein Localization | ✘ |
| Gene Expression | ✘ |
| Translational Efficiency | ✘ |
Endocytosis
| Temp | Actin Patch (Sac6-tdTomato) | Cortical Patch (Sla1-GFP) | Late Endosome (Snf7-GFP) | Vacuole (Vph1-GFP) |
|---|---|---|---|---|
| 37℃ | ||||
| RT |
Cell Cycle Omics
CYCLoPs (Lsm7-GFP)
| Gene / Allele | Actin Patch (Sac6-tdTomato) | Cortical Patch (Sla1-GFP) | Late Endosome (Snf7-GFP) | Vacuole (Sac6-tdTomato) |
|---|
| Gene | Images |
|---|
| Gene | Images |
|---|
Images are not yet available
Images are not yet available